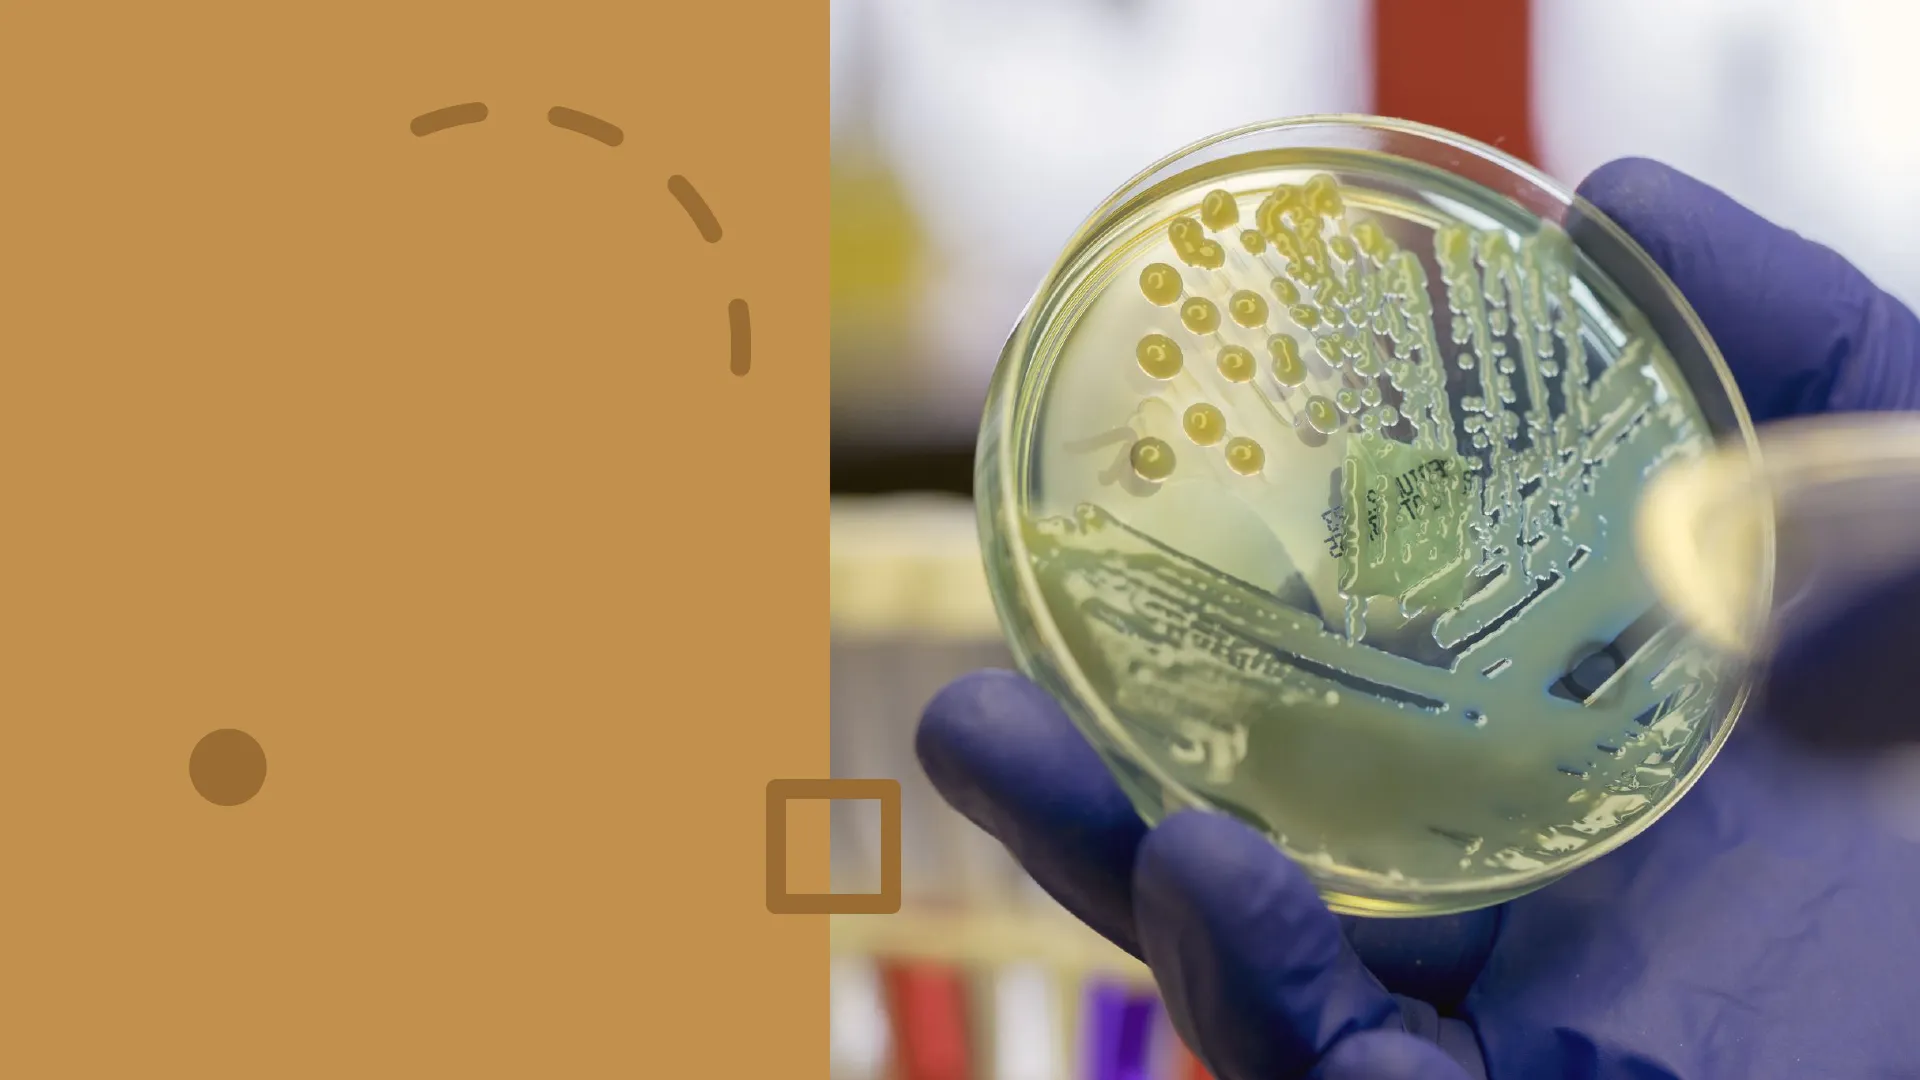

Microbiología: origen, clasificación y reproducción de bacterias
Diapositivas de Universidad sobre Microbiología. El Pdf detalla el origen y clasificación de microorganismos, la relación con otros seres vivos y la reproducción bacteriana, incluyendo la bipartición y formas de resistencia como las endosporas. Este material de Biología es ideal para el estudio universitario.
Ver más68 páginas

Visualiza gratis el PDF completo
Regístrate para acceder al documento completo y transformarlo con la IA.
Vista previa
Microbiología: Origen y Clasificación
O MicrobiologíaSESIÓN 1:
- ORIGEN DE LA MICROBIOLOGÍA.
- CLASIFICACIÓN DE MICROORGANISMOS
- LOS MICROORGANISMOS Y SU RELACION CON OTROS SERES VIVOS
- LAS BACTERIASCENTÍMETROS
Lente y Posicionamiento de Muestras
Lente 2 Localización de la muestra en un alfiler 31 4 Tornillo de posicionamiento de la muestra Control del foco 6 7 Tornillo de posicionamiento de la platina 81 10
Definición e Inicios de la Microbiología
· Ciencia que se encarga del estudio y análisis de los microorganismos · Mycros=pequeño bios=vida Microbiología · Inicios de la microbiología · Leeuwenhoek- descubridor de los microorganismos · Pasteur - desecha la generación espontánea fig : A - .D fig : B S" fig G. fig: E: F
Aportaciones de Louis Pasteur (1822-1895)
:Aportaciones de Louis Pasteur (1822-1895) · Inicia la microbiología desechando la generación espontánea · Inventa la pasteurización · Desarrolla la fermentación • Desarrollo la vacunación O Experimentación de vacunas en pollos (cólera aviar) O Experimentación de humanos (rabia) -> fabricación a partir del propio patógeno
Edad de Oro de la Microbiología: Hitos y Descubrimientos
1857 1861 1864 1867 1876 1879 1881 Koch *- Cultivos puros Pasteur-Fermentación Pasteur-Refutó la generación espontánea Pasteur-Pasteurización Lister-Cirugía aséptica Koch *- Teoría germinal de la enfermedad Neisser-Neisseria gonorrhoeae 1882 Koch *- Mycobacterium tuberculosis Hess-Medio sólido (agar) Joseph Lister (1827-1912) 1883 1884 Metchnikoff *- Fagocitosis Gram-Procedimiento de la coloración de Gram Escherich-Escherichia coli Petri-Placa de Petri 1887 1889 1890 Kitasato-Clostridium tetani Von Bering *- Antitoxina diftérica Ehrlich *- Teoría de la inmunidad Winogradsky-Ciclo del azufre Shiga-Shigella dysenteriae Ehrlich *- Sífilis 1892 1898 1908 1910 1911 Chagas-Trypanosoma cruzi Rous *- Virus productores de tumores. (Premio Nobel 1966) Robert Koch (1843-1910) Estableció pasos experimentales para la relación directa de un microbio con una enfermedad específica. Louis Pasteur (1822-1895) Demostró que la vida no se originó de modo espontáneo a partir de materia no viva. Edad de Oro de la MICROBIOLOGÍA Koch *- Vibrio cholerae Realizó la cirugía en condiciones asépticas mediante el empleo de fenol. Demostró que los microbios causaban infecciones de las heridas quirúrgicas. Finlay-Fiebre amarilla
Organización Celular y Acelular
Organización Celular: Reinos y Características
ORGANIZACIÓN CELULAR Poseen membrana, metabolismo y los dos ácidos nuclécos Procariótica REINO MÓNERAS ARQUEOBACTERIAS EUBACTERIAS Eucariótica REINO PROTOCTISTAS PROTOZOOS, ALGAS MICROSCÓPICAS (ALGAS VERDES, DIATOMEAS, ) REINO FUNGI HONGOS MICROSCÓPICOS
Organización Acelular: Parásitos Obligados
ORGANIZACIÓN ACELULAR No poseen membrana ni metabolismo y solo tienen un tipo de ácido nucleico. Son parásitos obligados · Virus (proteínas+ADN o ARN) · Viroides(ARN) · Priones(proteínas
Microorganismos y su Relación con Seres Vivos
Tipos de Relaciones: Patógenos, Simbiosis y Saprofitismo
3. LOS MICROORGANISMOS Y SU RELACIÓN CON LOS SERES VIVOS PATOGENO Y PATOGENO OPORTUNISTA PARASITISMO SIMBIOSIS SAPROFITISMO
Patógenos y Patógenos Oportunistas
PATÓGENO Microorganismo capaz de producir una enfermedad en un organismo llamado hospedador. ¿A que organismos se les considera patógenos? BACTERIAS, VIRUS , HONGOS Y PROTOZOOS. ALGUNAS ALGAS OPORTUNISTA Microorganismo que puede provocar enfermedad cuando las defensas del hospedador se ven debilitadas por una inmunodeficiencia. Ejemplos: Pseudomonas: oportunista más frecuente en infecciones hospitalarias Infecciones nosocomiales Citomegalovirus (pertenece a la familia de los herpes virus ): oportunista de enfermos del SIDA CMV produce enfermedades en diferentes órganos, principalmente cuando el conteo de linfocitos T CD4+ es muy bajo.
Parasitismo: Asociación Perjudicial
PARASITISMO: Es una asociación entre dos organismos de distinta especie en la que uno (PARÁSITO) se beneficia a otro (HOSPEDADOR) al que perjudica. Ejemplo: Cualquier microorganismo patógeno (Streptococcus pneumoniae): neumonía RELACION PERJUDICIAL Rickettsia causante del tifus Normal air sacs 0 Inflamed air sacs filled with fluid (pneumonia) Lungs O MAYO FOUNDATION FOR MEDICAL EDUCATION AND RESEARCH. ALL RIGHTS RESERVED.
Simbiosis: Asociación Beneficiosa
RELACION BENEFICIOSA SIMBIOSIS: Asociación entre dos organismos de distinta especie (microorganismos simbióticos) en la que se benefician mutuamente. -Ejemplos: MICROBIOTA INTESTINAL Lactobacilos y Bifidobacterias, E.coli ** Consumo de antibióticos flora v Bacterias con el ser humano * Consumo de yogures, probióticos flora MICROBIOTA VAGINAL Bacterias (bacilo de Doderlein) y hongos (Candida albicans) -> generan pH adecuado -> protegen de otros patógenos v Bacterias (Rhizobium) con plantas (leguminosas) -> fijación del N Leguminosas: Plantas dicotiledóneas, cultivadas o silvestres, que tienen como característica distintiva la de formar como fruto una vaina, en cuyo interior se alojan las semillas
Saprofitismo: Descomposición de Materia Muerta
SAPROFITISMO: Asociación entre dos organismos de distinta especie en a que uno se alimenta de otro (muerto) al que descompone. · Bacterias y hongos saprofitos Ej: Bacterias descomponedoras, Bacterias metanógenas (producen metano) y metanotróficas RELACION BENEFICIOSA ?
Las Bacterias
SESIÓN 1:
- ORIGEN DE LA MICROBIOLOGÍA.
- CLASIFICACIÓN DE MICROORGANISMOS
- LOS MICROORGANISMOS Y SU RELACION CON OTROS SERES VIVOS
- LAS BACTERIAS
Tipos de Bacterias: Arqueobacterias y Eubacterias
4.1 TIPOS DE BACTERIAS: v Grupo de microorganismos muy abundante y heterogéneo. v Todas las bacterias presentan organización procariota. División por Grupos filogenéticos (bioquímica y genéticamente) : ARQUEOBACTERIAS (Dominio Archaea) EJEMPLOS: Termófilas, metanógenas halófilas etc .. EUBACTERIAS (Dominio Bacteria): EJEMPLOS: Salmonella, Escherichia coli.
Arqueobacterias: Adaptación a Ambientes Extremos
ARQUEOBACTERIAS (Dominio Archaea) · Adaptados a vivir en ambientes de características extremas de temperatura, pH ... · Poseen la pared celular formada por un compuesto similar al peptidoglicano de las bacterias, por lo que se denomina pseudopeptidoglicano. Las paredes de las Archaea son resistentes naturalmente a la lisozima, debido a la ausencia de peptidoglicano. Ejemplo: las bacterias halófilas del Mar Muerto
Eubacterias: Autótrofas y Heterótrofas
EUBACTERIAS (Dominio Bacteria): · Pueden ser seres autótrofos (foto o quimiosintéticos) o heterótrofos (saprofitas, simbiontes o parásitas). Ejemplo, Salmonella, Escherichia coli, ... · Pueden realizar endosimbiosis. Por ejemplo, la Anabaena, que vive en simbiosis en el helecho acuático Azolla al que le aporta el nitrógeno que le falta
Forma de las Bacterias: Cocos, Bacilos, Espirilos y Vibrios
4.2. FORMA DE LAS BACTERIAS Coco Diplococos Estreptococos Tétradas Estafilococos Sarcinas Cocos Bacilo Diplobacilos Estreptobacilos Bacilos Espirilo Vibrio Espiroquetas Vibrios Espirilos
Cocos: Forma Redondeada y Modo de Vida
4.2. FORMA DE LAS BACTERIAS FORMA RELACIÓN ENTRE EJEMPLO FORMA Y MODO DE VIDA ENFERMEDAD Coco Diplococos Estreptococos Tétradas Estafilococos Sarcinas Cocos -Forma redondeada (poca relación Streptococcus Neumonía pneumoniae superficie/volumen) -Poca relación con el exterior. -Viven en medios ricos en nutrientes -Transmisión aérea / MUY resistentes/ Patógenas
Bacilos: Forma Alargada y Obtención de Nutrientes
4.2. FORMA DE LAS BACTERIAS FORMA RELACIÓN ENTRE EJEMPLO FORMA Y MODO DE VIDA ENFERMEDAD Bacilo Diplobacilos Estreptobacilos Bacilos -Forma Mycobacterium Tuberculosis alargada/cilíndrica tuberculosi (mayor relación superficie/volumen). -Obtención mas eficaz de nutrientes -Viven en medios pobres en nutrientes (suelos, aguas) -Menos resistentes /saprofitas
Espirilos y Vibrios: Movilidad y Patogenicidad
4.2. FORMA DE LAS BACTERIAS FORMA RELACIÓN ENTRE FORMA Y MODO DE VIDA EJEMPLO ENFERMEDAD Espirilo -Forma de hélice Treponema pallidum Sífilis -Viven en medios viscosos Vibrio -Pequeño diámetro -Atraviesan fácilmente mucosas Vibrio cholerae Cólera Espiroquetas Vibrios Espirilos
Estructura de las Bacterias: Componentes Clave
4.3. ESTRUCTURA DE LAS BACTERIAS Cápsula Pared celular Pilus La ilustración que se muestra abajo y la microfotografía de la derecha revelan un corte longitudinal de una bacteria, con su composición interna. No todas las bacterias tienen todas las estructuras que se muestran aquí; solo las estructuras en rojo se presentan en todas las bacterias. Aunque el nucleoide aparece separado en la microfotografía, el espesor del "corte" no transmite la profundi- dad del objeto. Citoplasma Ribosomas 70S Membrana plasmática Pared celular Nucleoide que contiene DNA Cápsula Inclusiones MET 0,5 um Plásmido Fimbrias Cápsula Pared celular ! La rotación de los flagelos bacterianos impulsa la célula a través de un medio acuoso Membrana plasmática
Cápsula Bacteriana: Composición y Función Protectora
4.3. ESTRUCTURA DE LAS BACTERIAS Cápsula Pared celular Membrana plasmática Cápsula: -Presente en casi todas las bacterias (sobre todo patógenas). -Compuesta por sustancias glucídicas (polímeros de glucosa, glucoproteínas ... )= glucocálix. - Tiene función protectora de la desecación, de la fagocitosis o del ataque de anticuerpos, regulación del intercambio de agua, iones y nutrientes, ...
Bacterias Gram-Positivas: Pared Celular y Tinción
GRAM+ Tinción azul oscuro o violeta Ácido teicoico w eve wve we MAM MAS NAG MAM MAM MAÇ MAM MAM MAM NAG MA MAM MAM N MAM NAG MAN MAM MAM MAM MAL MAM NAĞ MAN MAM Membrana plasmática · La envoltura celular de las bacterias Gram-positivas comprende la membrana citoplasmática y una pared celular compuesta por una gruesa capa de peptidoglucano, que rodea a la anterior. · La pared celular se une a la membrana citoplasmática mediante moléculas de ácido teicoico. · La capa de peptidoglicano confiere una gran resistencia a estas bacterias y es la responsable de retener el tinte durante la tinción de Gram NAG NAG MAM MAM Peptidoglucanos MAM
Ejemplos de Bacterias Gram-Positivas
GRAM+ Tinción azul oscuro o violeta EJEMPLOS: Streptococcus pneumoniae. Responsable de neumonías e infecciones en las vías respiratorias, así como otitis, meningitis y peritonitis. Clostridium tetani. Bacterias responsables de los tétanos, entran al cuerpo desde el suelo por traumatismos en las extremidades.
Bacterias Gram-Negativas: Envoltura Celular y Tinción
GRAM- Tinción color rosado Lipopolisacáridos Lípido A Lipoproteína Membrana externa Periplasma Peptidoglucanos - - - - - - - - - - MAAAA - - - - Membrana interna · Envoltura celular -> doble membrana celular (una externa y la otra citoplasmática) + fina pared celular de peptidoglicano *al ser la pared fina, no retiene el colorante. EJEMPLOS: gonorrea (Neisseria gonorrhoeae), la meningitis (Neisseria meningitidis)
Componentes Internos y Externos de la Célula Bacteriana
4.3. ESTRUCTURA DE LAS BACTERIAS Membrana plasmática Célula bacteriana Pared celular Nucleoide (ADN) Cápsula Flagelo Ribosoma Plásmido Pili Citoplasma lifeder .com MEMBRANA PLASMÁTICA formada por una bicapa de lípidos atravesada por proteínas, pero no contiene colesterol · RIBOSOMAS 70 S · INCLUSIONES CITOPLASMÁTICAS · PLÁSMIDO · EPISOMA CITOPLASMA ESTRUCTURAS EXTERNAS DE LA CÉLULA FLAGELOS (bacterias móviles) FIMBRIAS (adherencia) PILI (intercambio de ADN)